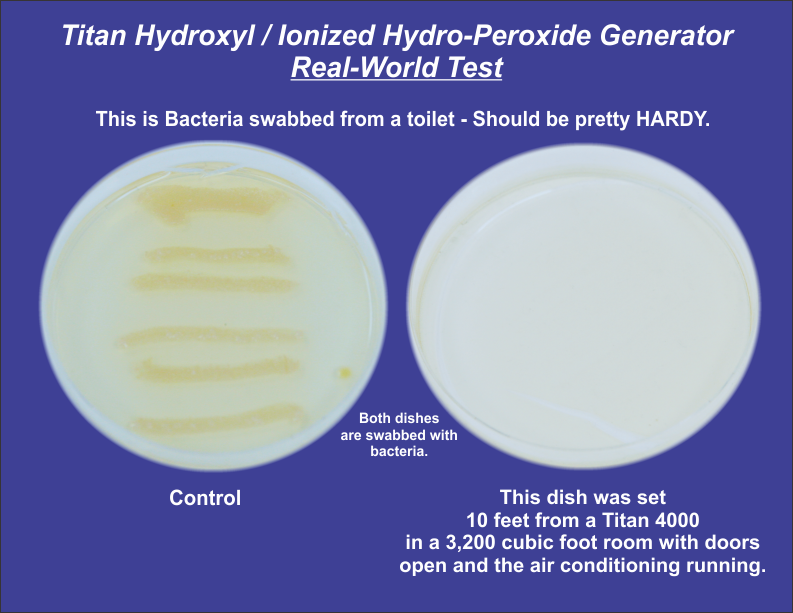

|
|
Home I About I Products I Find A Dealer I Resources I News I Contact |
|

IOTG, Inc Receives Copyright on Slogan "REAL-TIME SANITATION".
IOTG Is Proud to Support These Wonderful
Humanitarian Organizations.
![]() |
||
|
IOTG Donated two Titan 2000 Max Hydroxyl / Ionized Hydro-Peroxide Systems to Family Promise of Great Johnson City, Tennessee to help protect the families during these trying times. |
||
![]() |
||

|
|
|
![]() |
![]() |
© International Ozone Technologies Group, Inc 2020